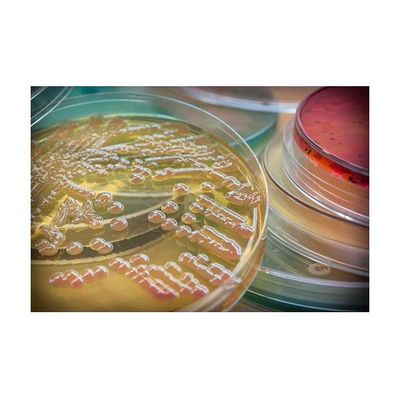

- Home
- Companies
- Vaxdyn, S. L.
- Products
- AcinetoVax - Model VXD001 - Inactivated ...
AcinetoVax - Model VXD001 -Inactivated LPS-null (endotoxin free) Whole-Cell Acinetobacter Baumannii Vaccine
Active principle: Inactivated LPS-null (endotoxin free) whole-cell Acinetobacter baumannii vaccine. Stage: Preclinical development. Indication: Raise active immunity against 100% of circulating strains of Acinetobacter baumannii, in the population in hospitals or the community at risk of developing infections by A. baumannii. Highlights: Multi-antigen presentation leads to potent humoral and cell-mediated immunity, 100% protective in animal models. Two well conserved immunodominant Outer-Membrane Proteins (OMPs) identified as the major contributors to protective immunity. The absence of LPS and conservation of the immunodominant OMPs lead to vaccine universality (high strain coverage). Manufacturing process developed. The drug substance does not need purification, since it is based on whole cells.
